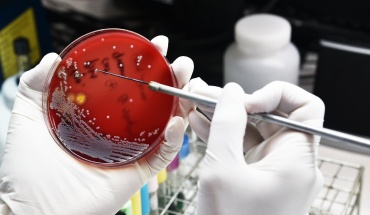

Η ποιότητα σπέρματος σημαντική για την επιτυχία εξωσωματικής
02 Ιουλίου 2019, 14:35

Για την επιτυχία μιας εξωσωματικής γονιμοποίησης δεν παίζει ρόλο μόνο η ηλικία της μητέρας, αλλά και του πατέρα, σύμφωνα με νέα βρετανική επιστημονική μελέτη η οποία δείχνει ότι η πιθανότητα επιτυχίας της υποβοηθούμενης αναπαραγωγής μειώνεται σημαντικά, αν ο πατέρας είναι άνω των 51 ετών.
Προηγούμενες μελέτες έχουν δείξει ότι η ποιότητα του σπέρματος γίνεται χειρότερη με το πέρασμα του χρόνου και ότι μπορεί να αυξηθούν οι γενετικές βλάβες στα σπερματοζωάρια του άνδρα. Όσο ο άνδρας γερνάει, η ανδρική γονιμότητα μειώνεται και αυξάνεται η πιθανότητα αποβολής της γυναίκας σε περίπτωση φυσικού τοκετού. Η νέα έρευνα δείχνει ότι υπάρχουν επιπτώσεις από την ηλικία του άνδρα και στις περιπτώσεις εξωσωματικής γονιμοποίησης.
Οι ερευνητές, με επικεφαλής τον δρα Γκάι Μόρις του Κέντρου Αναπαραγωγικής και Γενετικής Υγείας του Λονδίνου, που έκαναν τη σχετική ανακοίνωση στο ετήσιο συνέδριο της Ευρωπαϊκής Εταιρείας Ανθρώπινης Αναπαραγωγής και Εμβρυολογίας στη Βιέννη, ανέλυσαν στοιχεία για 4.271 άνδρες που συμμετείχαν σε 4.833 κύκλους υποβοηθούμενης αναπαραγωγής μεταξύ 2009-2018.
Διαπιστώθηκε κατ' αρχήν, όπως αναμενόταν, ότι το ποσοστό που μια εξωσωματική καταλήγει σε εγκυμοσύνη, μειώνεται ανάλογα με την ηλικία της μητέρας, από 51% για τις γυναίκες κάτω των 35 ετών, σε 22% για εκείνες άνω των 40 ετών. Κάτι ανάλογο όμως συμβαίνει και με την ηλικία του πατέρα, με το ποσοστό επιτυχούς εξωσωματικής να μειώνεται από 50% για τους άνδρες έως 35 ετών, σε 42,5% για τις ηλικίες 36-40, 35,2% για τις ηλικίες 41-45, 32,8% για τις ηλικίες 46-50 και 30,5% για τους άνω των 50 ετών.
Ως εκ τούτου, μερικές κλινικές γονιμότητας βάζουν όριο στην ηλικία των δωρητών σπέρματος, συνήθως έως τα 40 έτη.